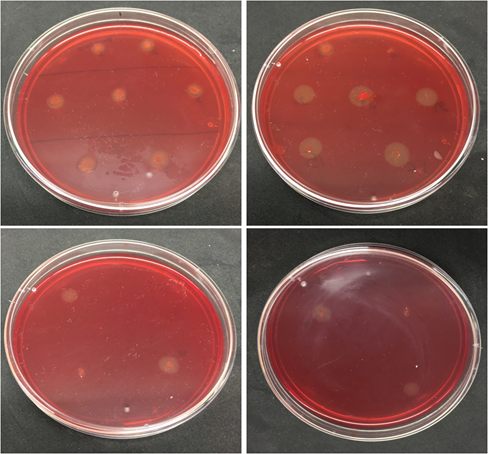

Journal of
eISSN: 2572-8466


Research Article Volume 6 Issue 3
University School of Biotechnology, Guru Gobind Singh Indraprastha University, India
Correspondence: Prakash Chand Sharma, University School of Biotechnology, Guru Gobind Singh Indraprastha University, New Delhi, 110078, India, Tel 91-11-25302306, , Fax +91-11-25302111
Received: March 14, 2019 | Published: May 13, 2019
Citation: Goel N, Patra R, Verma SK, et al. Purification and characterization of cellulase from Pseudomonas sp. isolated from waste dumping site soil. J Appl Biotechnol Bioeng. 2019;6(3):118-124. DOI: 10.15406/jabb.2019.06.00183
Cellulases along with proteases and lipases account for a significant share in the global enzyme market. Microbial cellulases have important applications in industries like fodder, food, textile, brewery, pulp and paper. The present study, therefore, was undertaken to purify and characterize callulase enzyme from the cellulolytic microbes isolated from a waste dumping site. Of the 28 microbial isolates, five isolates produced cellulase on LB agar plates containing 1% CMC. The PCS-22 isolate, representing Pseudomonas sp. was selected for further purification and characterization of cellulase produced. The enzyme was purified using anion exchange chromatography. The molecular weight of the purified enzyme was approximately 60 kDa. The purified enzyme showed maximum activity and stability at 50°C and pH 7.0. Inhibition of enzymatic activity was observed in the presence of Zn2+, Cu2+ and Fe2+ ions while the presence of Mn2+ ions caused a three-fold increase in the activity. The effect of inhibitors (PMSF, EDTA, β-mercaptoethanol), surfactants (TritonX-100 and SDS) and commercial detergents (Tide and Surf Excel) on the stability of the purified enzyme was also studied.
Keywords: Cellulase, Cellulolytic bacteria, 16S rRNA gene, Pseudomonas sp., enzyme characterization
Cellulases carry out hydrolysis of cellulose to liberate simple sugars. Cellulase is a complex enzyme which requires synergistic action of endoglucanase, exoglucanase and β-glucosidase.1 Currently, commercial cellulases are obtained from some species of fungi and bacteria. Comparatively, bacterial species have better growth rate and resistance to extreme environments.2–4 Microbial cellulases have applications in many industries, particularly in textile industry, pulp and paper industry, food industry and detergent industry as well as in cellulosic waste management.5–7 Cellulases also play an important role in the hydrolysis of renewable lignocellulosic waste materials for the production of biofuels like bioethanl.8 There is an ever increasing need for cost-effective production and identification of new sources of cellulases. Therefore, the present study was undertaken to isolate potential cellulose degrading bacteria from cellulosic waste dumping site soil. Selected bacterial isolates were screened for the endoglucanase enzyme activity using CMCase (carboxymethyl cellulase) assay. Cellulose producing Pseudomonas sp. are reported in very limited articles, although Pseudomonas can utilize cellulose as main carbon source and may serve profitably as a biological agent for isolation of cellulase enzyme.9 Therefore, the cellulase enzyme was purified from Pseudomonas sp., and various parameters for its optimum activity were characterized.
Sample collection and processing
A soil sample from 5-10 cm depth was collected in a sterile plastic bag from waste dumping site, Dwarka Sector-13, New Delhi (28°36’15” N, 77°2’9”E) and transported to the laboratory at 4°C. The soil sample was sieved through 0.2 mm mesh and stored at -20°C.
Isolation and screening of cellulolytic bacteria
Soil suspension was prepared by suspending 1 g soil into 9.0 ml sterile distilled water to set up 10-fold serial dilutions.10–11 Soil suspension (0.1ml) was spread on to LB agar plates containing 1% CMC and incubated overnight at 37°C. After ensuring sufficient growth, selected bacterial colonies were again streaked on to LB agar plates containing 1%CMC. The LB plates were incubated for 48 h at 37°C. Incubated plates were stained with 1% Congo red solution and allowed to shake on multi bio 3D shaker (Biosan) at room temperature for 15min and destained for 20min using 1M NaCl to obtain clear halo zone of hydrolysis around the colonies. Cellulose degrading bacterial isolates were selected by calculating high ICMC values (diameter of halo zone/colony diameter) and streaked on to LB agar plates containing 1% CMC CMC.10
Molecular identification and construction of phylogenetic trees of bacterial isolates
Genomic DNA of all five bacterial isolates was extracted following Patagundi et al.,11 16S rRNA gene was PCR amplified in mastercycler (Eppendorf) from the extracted DNA template using universal forward primer B27F (5’- AGA GTT TGA TCC TGG CTC AG -3’) and reverse primer U1492R (5’- CGG TTA CCT TGT TAC GAC TT -3’).12 The amplified gel extracted products were outsourced for Sanger sequencing to Xcelris Labs Ltd., Ahmedabad, Gujarat. Phylogenetic trees were constructed using 16S rRNA gene sequences using NCBI Basic Local Alignment Search Tool (BLAST). MEGA 7 software was used for the identification of bacterial isolates.
Enzyme assay using DNS method
Five bacterial isolates having maximum clearance zone were selected for cellulase enzyme assay. Enzyme activity was measured by estimating reducing sugar released from CMC using dinitrosallicylic acid (DNS) reagent.13 The supernatant of the 24h culture was collected by centrifugation at 10,500 rpm for 10 min at 4°C and used as crude enzyme. 0.5ml crude enzyme solution of each bacterial isolate was mixed with 0.5ml 1% CMC (0.05M phosphate buffer, pH 7.0) and incubated at 50°C for 30min. 3ml of DNS reagent was added to the mixture to stop the reaction. The mixture was boiled at 100°C for 10 min in a water bath. Absorbance of the mixture was recorded at 540nm to estimate the enzyme activity using glucose standard curve.
Process optimization for maximum enzyme activity in crude enzyme
To optimize the reaction parameters, enzyme assay was performed at different temperatures, pH and substrate concentrations. To determine enzyme activity at different temperatures, 0.5 ml crude enzyme was mixed with 0.5ml 1% CMC and enzyme assay was performed at 25°C, 37°C, 50°C, 65°C, 80°C and 90°C for 30min. For pH optimization, enzyme assay was performed at pH 3.0, 5.0, 7.0, 9.0 and 11.0. To optimize the suitable substrate concentration for maximum crude enzyme activity, 0.5%, 1.0% and 1.5% concentrations of CMC were used.
Purification of cellulase from Pseudomonas sp. isolate PCS-22
The crude enzyme was extracted from 24 h culture maintained under optimal conditions. The crude enzyme was precipitated overnight using ammonium sulphate (40% and 80% saturation) and centrifuged at 10,500 rpm for 10 min at 4°C to collect the pellets. The pellets were suspended in a minimal amount of 50 mM phosphate buffer (pH 7.0) and dialyzed overnight. Anion exchange chromatography of the dialyzed sample was performed using DEAE-Cellulose column equilibrated with phosphate buffer (pH 8.0). The column was left at 4°C for 2–3h to allow the binding of the enzyme. Unbound fractions were collected, and column was washed with phosphate buffer (pH 8.0). Gradient elution of the bound fractions was performed using 0.2M to 1.0M NaCl. Protein content and enzyme activity of each fraction was measured. The protein content was measured by Folin-Lowry method using BSA (Bovine serum albumin) standard curve.14 The temperature was maintained at 4°C throughout the purification process. Sodium dodecyl sulphate - polyacrylamide gel electrophoresis (SDS-PAGE) SDS-PAGE was performed on crude enzyme, 0-40% ammonium sulphate precipitated fraction after dialysis, and the fraction having maximum activity obtained from anion exchange chromatography along with BLUelf prestained ladder (245 kDa, GeneDirex) using 10% resolving and 4% stacking polyacrylamide gels.15
Characterization of purified cellulase
Effect of temperature on the activity and stability of the purified enzyme
To assess the effect of temperature on the enzyme activity, reaction mixture of substrate and enzyme was incubated at 30°C, 40°C, 50°C, 60°C, 70°C, 80°C and 90°C temperature for 30min and the DNS method was used to determine the enzyme activity as mentioned earlier. Effect of temperature on enzyme stability was assessed by pre-incubating the enzyme at different temperatures (30°C, 40°C, 50°C, 60°C, 70°C, 80°C and 90°C) for 1 h and the residual enzyme activity was calculated by carrying out the reaction of enzyme and substrate at 50°C and pH 7.0.13,15
Effect of pH on the activity and stability of the purified enzyme
To assess the effect of pH, the reaction mixture of substrate and enzyme was incubated at various pH (3.0, 4.0, 5.0, 5.5, 6.0, 6.5, 7.0, 7.5, 8.0, 9.0 and 10.0) for 30min at 50°C and the activity of the purified enzyme was calculated using DNS method. Effect of pH on enzyme stability was assessed by pre-incubating the enzyme at 50°C for 1 h at different pH (3.0, 4.0, 5.0, 5.5, 6.0, 6.5, 7.0, 7.5, 8.0, 9.0, and 10.0) and the residual enzyme activity was calculated by carrying out the reaction of enzyme and substrate at 50°C and pH 7.0.13,15
Effect of metal ions on the activity of the purified enzyme
The effect of metal ions on the activity of the purified enzyme was studied by performing the standard reaction of the substrate and the enzyme at 50°C for 30 min at pH 7.0 in the presence of various salts (KCl, NaCl, CaCl2, MnCl2, CuSO4, FeSO4 and ZnSO4) at different concentrations 1mM, 5mM and 10mM.13,15
Effect of inhibitors, surfactant and commercial detergents on the stability of the enzyme
To assess the effect of inhibitors (phenylmethylsulfonyl fluoride (PMSF), ethylenediaminetetraacetate (EDTA), β-mercaptoethanol), surfactants (Tween-20, TritonX-100, SDS) and commercial detergents (Tide, Surf Excel) on enzyme stability at different concentrations, enzyme was pre-incubated for 1 h in the presence of particular compound at 50°C and the residual enzyme activity was calculated by carrying out the standard reaction of enzyme and substrate at 50°C and pH 7.0.13,15
Isolation, screening and identification of cellulolytic bacteria
In total, 28 bacterial isolates were initially selected from serially diluted soil sample showing halo zones on the LB agar plates containing 1% CMC after staining with 1% Congo red solution (Supplementary Figure 1). Of these, five bacterial isolates (PCS-15, PCS-16, PCS-20, PCS-22, and PCS-28) were selected on the basis of high ICMC value for further analysis as shown in Table 1.
Supplementary Figure 1 Clear halo zones produced after Congo red staining due to hydrolysis of cellulose by bacterial isolates on LB agar plates containing 1% CMC.
Bacterial isolate |
Diameter of bacterial colony (cm) |
Diameter of halo zone (cm) |
ICMC value |
PCS-1 |
0.20 |
0.30 |
1.50 |
PCS-2 |
0.20 |
0.40 |
2.00 |
PCS-3 |
0.20 |
0.30 |
1.50 |
PCS-4 |
0.20 |
0.30 |
1.50 |
PCS-5 |
0.15 |
0.30 |
2.00 |
PCS-6 |
0.20 |
0.30 |
1.50 |
PCS-7 |
0.15 |
0.30 |
2.00 |
PCS-8 |
0.15 |
0.30 |
2.00 |
PCS-9 |
0.20 |
- |
- |
PCS-10 |
0.10 |
0.15 |
1.50 |
PCS-11 |
0.10 |
0.20 |
2.00 |
PCS-12 |
0.15 |
0.20 |
1.33 |
PCS-13 |
0.20 |
- |
- |
PCS-14 |
0.20 |
0.30 |
1.50 |
PCS-15 |
0.20 |
0.55 |
2.75 |
PCS-16 |
0.20 |
0.50 |
2.50 |
PCS-17 |
0.25 |
- |
- |
PCS-18 |
0.15 |
0.20 |
1.33 |
PCS-19 |
0.20 |
0.25 |
1.25 |
PCS-20 |
0.25 |
0.55 |
2.20 |
PCS-21 |
0.20 |
- |
- |
PCS-22 |
0.15 |
0.42 |
2.80 |
PCS-23 |
0.30 |
- |
- |
PCS-24 |
0.15 |
0.30 |
2.00 |
PCS-25 |
0.20 |
0.40 |
2.00 |
PCS-26 |
0.20 |
- |
- |
PCS-27 |
0.20 |
0.40 |
2.00 |
PCS-28 |
0.20 |
0.45 |
2.25 |
Table 1 Observations on diameter of bacterial isolates and halo zones around the colonies after Congo red staining
Genomic DNA of the bacterial colonies was extracted and loaded on to 1% agarose gel containing 3µl of ethidium bromide (10 mg/ml) to assess the quality of DNA (Figure 1A). The genomic DNA extracted from these bacteria was used to amplify 16S rRNA gene. The PCR amplified products of approximately 1.5 kb were resolved on 1.2% agarose gel (Figure 1B). Amplified PCR products were gel eluted and outsourced for Sanger sequencing. The sequences obtained in fasta format were analysed using NCBI nucleotide BLAST tool and compared with the known NCBI database sequences. Fourteen similar sequences (97-99%) for each isolate were used to construct the phylogenetic tree. Phylogenetic tree for each isolate was constructed by neighbor joining method using MEGA 7.0 software. According to the phylogenetic trees shown in Supplementary Figures 2–5, PCS-15, PCS-16, PCS-20 and PCS-28 isolates were found matching with Bacillus species, while PCS-22 isolate represented a Pseudomonas species (Figure 2).

Supplementary Figure 2 Phylogenetic tree showing relationship between isolate PCS-15 and other Bacillus strains.

Supplementary Figure 3 Phylogenetic tree showing relationship between isolate PCS-16 and other Bacillus strains.

Supplementary Figure 4 Phylogenetic tree showing relationship between isolate PCS-20 and other Bacillus strains.

Supplementary Figure 5 Phylogenetic tree showing relationship between isolate PCS-28 and other Bacillus strains.

Figure 1 (a) Genomic DNA extracted from bacterial isolates. Lane M: HindIII digested lambda molecular marker; Lane 1: PCS-15; Lane 2: PCS-16; Lane 3: PCS-20; Lane 4: PCS-22; and Lane 5: PCS-28 isolate.
(b) PCR amplified products of 16S rRNA gene. Lane M:- 1 kb DNA ladder; Lane 1: PCS-15; Lane 2: PCS-16; Lane 3: PCS-20; Lane 4: PCS-22; and Lane 5: PCS-28.

Figure 2 Phylogenetic tree showing the relationship between bacterial isolate PCS-22 and other Pseudomonas strains.
Process optimization for maximum enzyme activity in crude enzyme
According to the results shown in Figure 3A, four bacterial isolates, PCS-15, PCS-20, PCS-22, and PCS-28 exhibited maximum activity at 50°C except PCS-16, which had maximum activity at 65°C. All the five bacterial isolates showed maximum activity at pH 7.0 (Figure 3B) and 1% substrate concentration (Figure 3C). Isolate PCS-15 showed maximum enzyme activity followed by PCS-22. Of the two, isolate PCS-22 was further selected for the purification and characterization of cellulase as cellulases from Pseudomonas sp. are scarcely reported in the literature.

Figure 3 Optimization of parameters for maximum crude enzyme activity.
(a) Temperature; (b) pH; and (c) substrate concentration.
Purification of cellulase from Pseudomonas sp. isolate PCS-22
Ammonium sulphate precipitation was performed with the culture free supernatant of PCS-22 isolate. Enzyme activity and protein concentration of both 0-40% and 40-80% precipitated fractions were measured by dissolving in 50 mM phosphate buffer (pH 7.0). Surprisingly, 0-40% fraction showed high activity comparative to that in 40-80% fraction. Contrary to this observation, maximum enzyme activity has been reported in 40-60% ammonium sulphate precipitation in the majority of the reports on bacterial cellulases.16 However, cellulase isolated from Pseudomonas fluorescens was precipitated at 90% ammonium sulphate saturation.17 Dialysis of 0-40% precipitated protein was performed to remove ammonium sulphate using 50 mM phosphate buffer (pH 7.0).
After dialysis, the sample was subjected to anion exchange chromatography using DEAE-Cellulose column. After washing unbound proteins with phosphate buffer (pH 8.0), bound proteins were eluted using a linear gradient of 0.2M to 1M NaCl in phosphate buffer (pH 8.0). Total enzyme activity and total protein concentration decreased with each purification step while specific activity increased subsequently as presented in Table 2. The maximum specific activity estimated was 0.757 with 14.52 purification fold. Earlier, Bakare et al.,17 & Itani et al.,18 reported maximum specific activity 3.57 and 3.15 with 23.80 and 24.20 purification fold for Pseudomonas fluorescens and Pseudomonas aeruginosa, respectively. Specific activity increased by approximately 300% during ammonium sulphate precipitation. Different steps during purification process resulted in the recovery of 37.7%, 36.0% and 33.4% portion of the enzyme by ammonium sulphate precipitation, dialysis and DEAE-Cellulose column chromatography, respectively.
Purification step |
Total activity (U) |
Total protein (mg) |
Specific activity (U/mg) |
Purification fold |
Yield (%) |
Crude |
34.740 |
666.900 |
0.052 |
1.00 |
100.0 |
Ammonium |
13.090 |
61.615 |
0.212 |
4.08 |
37.7 |
Dialysis |
12.523 |
35.138 |
0.356 |
6.84 |
36.0 |
DEAE-Cellulose |
11.616 |
15.354 |
0.757 |
14.52 |
33.4 |
Table 2 Purification profile of cellulase from Pseudomonas sp. isolate PCS-22
Specific activity = Total activity / Total protein
*Purification fold = Specific activity of particular purification step / Specific activity of the crude enzyme
*Yield (%) = (Total activity of the particular purification step / total activity of the crude enzyme) x 100
Sodium dodecyl sulphate - polyacrylamide gel electrophoresis (SDS-PAGE)
After purification, SDS PAGE was performed for crude enzyme, 0-40% precipitated protein after dialysis and purified enzyme. The band position in lane 3 (Figure 4) showed that the molecular weight of the purified enzyme to be approximately 60 kDa. Bakare et al. reported the molecular weight of homogeneous endoglucanase enzyme as 36 kDa.17 However, Gaur and Tiwari reported molecular weight of the cellulase from Bacillus vallismortis RG-07 as 80 kDa.3 The differences reported in the molecular weight may be due to the complexity of the isolated enzyme.

Figure 4 SDS PAGE of different fractions obtained during purification of cellulase. M: Prestained protein ladder; Lane 1: Crude enzyme; Lane 2: 0-40% ammonium sulphate precipitated protein; and Lane 3: Purified protein after anion exchange chromatography.
Characterization of purified cellulase
Effect of temperature on the activity and stability of the purified enzyme
According to the results shown in Figure 5A, maximum activity was recorded at 50°C which declined thereafter. The purified enzyme showed stability at a broad range of temperature when pre-incubated for 1 h. However, over 60°C, enzyme stability gradually decreased. The optimum stability was recorded at 50°C. This observation suggests that enzyme isolated in the present study could have a promising industrial prospective where cellulases effective at high temperature are required. An earlier study has reported optimum cellulase activity and stability from a Pseudomonas isolate at 30°C to 35°C.17
Effect of pH on the activity and stability of the purified enzyme
Effect of pH on enzyme activity and stability was studied by measuring enzyme activity at varying pH values using suitable buffers. It is evident from Figure 5B that the optimum pH for maximum activity of the purified enzyme was pH 7.0 although enzyme is active over pH 6.5 to pH 8.0. The enzyme was stable over a broad range of pH values, optimum being pH 7.0. Similar optimum activity was also observed for cellulase from Pseudomonas fluorescence.16 The cellulases earlier reported were generally stable over a wide range of pH from 5.0 to 10.0.3
Effect of metal ions on the activity of the purified enzyme
The presence of potassium, sodium and calcium ions significantly decreased the activity of the purified enzyme at 5mM and 10mM concentrations whereas activity was not much affected at 1mM concentration (Table 3). Enzyme activity was inhibited in the presence of copper, zinc and ferrous ions at 5mM and 10mM concentration whereas the activity was retained significantly at 1mM concentration. The activity of the enzyme was increased in the presence of manganese ions. As the manganese ions concentration was increased from 1 mM to 10 mM, the activity was increased more than three times when compared to control supporting an earlier report involving enzyme isolated from fungus Aspergillus flavus M15 isolate and Cellulomonas species ASN2, where enzyme activity was increased in the presence of manganese ions.19 These results suggest that manganese ions might be acting as a co-factor to enhance the activity of cellulase enzyme.
Metal ions |
Concentration (mM) |
Residual activity (%) |
Control |
|
100 |
KCl |
1 mM |
116.03 |
NaCl |
1 mM |
98.51 |
CaCl2 |
1 mM |
93.75 |
MnCl2 |
1 mM |
178.53 |
CuSO4 |
1 mM |
57.61 |
FeSO4 |
1 mM |
80.30 |
ZnSO4 |
1 mM |
66.30 |
Table 3 Effect of metal ions on enzyme activity
Effect of inhibitors, surfactant and commercial detergents on the stability of the enzyme
The stability of the purified enzyme was assessed in the presence of various detergents to assess its application in detergent industries. The enzyme lost its activity when pre-incubated in the presence of commercial detergents, Triton-X 100 and SDS at 5mM concentration for 1hr whereas at 1mM concentration, enzyme retained less than 50% activity indicating that enzyme was not stable in the presence of detergents. However, in the presence of non-ionic surfactant Tween-20, enzyme activity increased (Table 4). The enzyme was found to be stable in the presence of inhibitors such as β-mercaptoethanol and phenylmethylsulfonyl fluoride (PMSF) at 1mM concentration whereas it lost 20% of its activity at 5 mM concentration. Similar reports are available for cellulases isolated from Bacillus vallismortis RG-07.3 When incubated with ethylenediaminetetraacetate (EDTA) for 1h, enzyme activity decreased suggesting that EDTA worked as a chelating agent for the metal ions that were necessary for the enzyme activity.
Reagent |
Concentration (mM) |
Residual activity (%) |
Control |
|
100 |
β-Mercaptoethanol |
1 mM |
136.59 |
PMSF |
1 mM |
114.62 |
EDTA |
1 mM |
75.21 |
Tween-20 |
1 mM |
80.25 |
Triton X-100 |
1 mM |
- |
SDS |
1 mM |
37.16 |
Tide |
1 mM |
40.52 |
Surf Excel |
1 mM |
45.65 |
Table 4 Effect of inhibitors, surfactant and commercial detergents on the stability of purified enzyme
Five isolates of cellulolytic bacteria from waste dumping site soil were screened for their cellulose degrading ability. Cellulase enzyme of approximately 60 kDa molecular weight was purified from PCS-22 isolate representing Pseudomonas sp. which showed maximum enzyme activity at temperature 50°C and pH 7.0. The enzyme activity increased three-fold in the presence of Manganese ions, possibly acting as a cofactor for improved activity. Stability of the isolated enzyme at high temperature may potentially be exploited in various industrial applications. Further studies on the purified cellulase be conducted to assess its usefulness in the degradation of cellulosic waste also.
None.
Authors declare no conflict of interest.

©2019 Goel, et al. This is an open access article distributed under the terms of the, which permits unrestricted use, distribution, and build upon your work non-commercially.